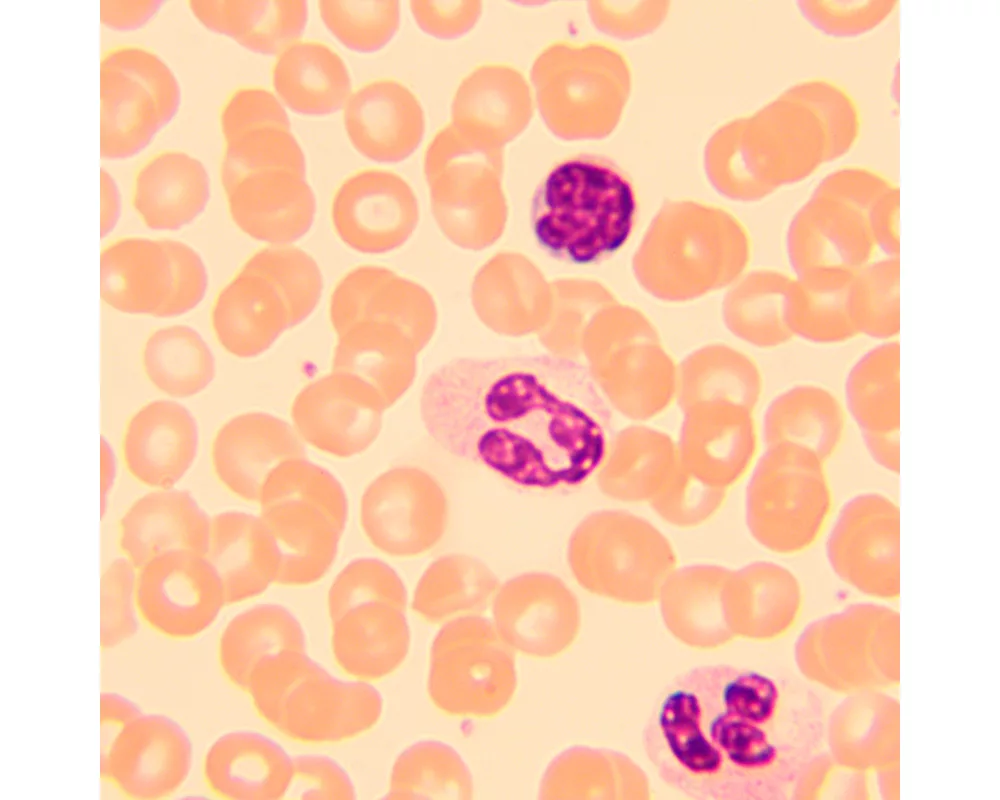
Микроскоп Биологичен цифров MAGUS Bio D250T LCD 36

- Начало
- Оптични уреди и измервателни инструменти
- Микроскопи
- Magus
- Биологичен цифров MAGUS Bio D250T LCD (ID: 693306)
Микроскоп Биологичен цифров MAGUS Bio D250T LCD 83009
планахроматични обективи с корекция до безкрайност, халогенна крушка 30 W
Гаранция:
0.0
от 5.0
(0)
Купи и събери
22 точки
Плати по-лесно и сигурно с
ID: 693306
Характеристики
| Тип | биологичен, светлина/оптичен, цифрови |
| Подходящо за | лабораторно/медицинско |
| Употреба | за професионалисти, опитни потребители |
| Монтаж и инсталиране | сложен |
| Technique | на светлото поле |
| Head | глава Gemel (Siedentopf, завъртане на 360°) |
| Head angle | 30 ° |
| Revolver | за 5 обектива |
| Увеличение, x | 40 — 1000 x |
| Окуляри | 10х/22 mm, разстояние от очите: 10 mm (*опция: 10x/22 mm със скала, 12,5x/14; 15x/15; 20x/12; 25x/9) |
| Диаметър на окуляра | 30 мм. |
| Диоптрична корекция на окуляра | ±5 (на лявата тръба) |
| Фокусиране | коаксиален, грубо фокусиране (21 mm, 39,8 mm/кръг, със застопоряващ бутон и бутон за регулиране на затягането) и фино фокусиране (0,002 mm) |
| Diaphragm | диафрагма с регулируема апертура, полева диафрагма с регулируем ирис |
| Objectives | планахроматични с корекция до безкрайност: 4x/0,10; 10x/0,25; 40xs/0,65; 100xs/1,25 (масло); парфокално разстояние: 45 mm (*опция: 20x/0,40; 60хs/0,80) |
| Филтри | да |
| Working distance | 21 (4x); 5 (10x); 0,66 (40xs); 0,36 (100xs); 8,8 (20x); 0,465 (60xs) mm |
| Разстояние между окулярите (IPD), mm | 48 — 75 мм. |
| Condenser |
кондензер Abbe
N.A. 1,25 с регулируем център регулируема височина диафрагма с регулируема апертура слот за плъзгач за метода на тъмното поле и плъзгач за фазовоконтрастно наблюдение монтировка тип „лястовича опашка“ |
| Light source type | халогенно |
| Light source | халогенна крушка 12 V/30 W, G4 |
| Light source placement | долно |
| Spectral range | 380–650 (вграден инфрачервен филтър) nm |
| Brightness control |
|
| Работна температура | -15 — 55 °С |
| Запис |
|
| Мегапиксели | 2 |
| Video format | *.h264, *.mp4 |
| Image format | *.jpg |
| Pixel size | 2.9x2.9 μm |
| Expansion | USB мишка, фазовоконтрастно устройство (кондензер и обективи), кондензер за метода на тъмното поле в имерсионно масло (сух или в масло), устройства за поляризация (поляризатор и анализатор) |
| Camera power supply | променливотоков адаптер 12 V, 1 A |
| Camera operating temperature | -10 — 50 °С |
| Stage | 180x150 мм. |
| Stage adjustment | 75/50 |
| Stage features | двуосова механична предметна маса, без рейка за позициониране |
| Размери на продукта | 43x27x63 cm см. |
| Системни изисквания | не изисква връзка с компютър |
| Захранване |
220±22 V
50 Hz променливотокова мрежа променливотоково 110 V–220 V/постояннотоково 5–12 V 1 A (Тип-C) |
| Материал | плътен алуминий |
| Тегло | 12.65 kg кг. |
| Гаранция | 24 месеца |
| Код на продукта | 83009 |
Виж повече
Допълнителна информация
<p>Биологичният микроскоп MAGUS Bio D250T LCD е професионален уред за наблюдение на биологични образци с пропускана светлина. Основният метод за изследване е методът на светлото поле (готов за употреба). Също са достъпни методите на тъмно поле, поляризация и фазов контраст, но за тях са необходими допълнителни принадлежности за микроскоп. Микроскопът е отличен за лабораторни и изследователски наблюдения в медицината, фармацевтиката, криминалистиката, селското стопанство и други области.</p>
<p><strong>Цифрова камера</strong></p>
<p>MAGUS CHD10 е най-достъпната камера с интерфейс HDMI.<br />
Камерата е оборудвана с 2 MP сензор и създава реалистични Full HD изображения с разделителна способност 1920x1080 пиксела.<br />
Тя е автономна камера, която не изисква свързване с компютър или инсталиране на допълнителен софтуер. Камерата може да се свърже директно към телевизор, монитор или проектор, за да покаже изображение.
Интерфейсът HDMI осигурява висока и стабилна скорост на предаване на данните от камерата към външния екран. Видеозапис се заснема с 60 fps.<br />
Камерата комбинира висока честота на кадрите в секунда и широколентов HDMI. Поради това видеозаписите са ярки, няма „замръзвания“ или прекъсвания между кадрите. При максимална разделителна способност изображението е с добра детайлност, движещите се обекти се виждат без проблеми, а движението на обектите се показва без закъснения.</p>
<p><strong>Течнокристален монитор</strong></p>
<p>Мониторът MAGUS MCD20 е предназначен за използване на системата за визуализация на микроскопа MAGUS.<br />
Той е свързан към камера, която е монтирана на микроскопа за показване на изображения в реално време. Поддържа HDMI камери MAGUS с разделителна способност Full HD.<br />
Диагоналът на екрана е 13,3 инча. IPS матрицата осигурява ярки изображения при големи ъгли на видимост. Ако погледнете към дисплея под ъгъл, възпроизвеждането на цветовете не е нарушено.<br />
Дисплеят може да се постави на сгъваема стойка върху маса или шкаф, или да се монтира директно към камерата или към стойката на микроскопа.</p>
<p><strong>Оптика</strong></p>
<p>Планахроматичните обективи осигуряват ясно, контрастно и детайлно изображение с минимално изкривяване. Увеличението с приложените обективи и окуляри е в диапазона от 40 до 1000x, а горната граница може да се увеличи с допълнителни окуляри. Оптичните елементи са коригирани до безкрайност, което означава, че на оптичния път могат да се монтират допълнителни принадлежности.</p>
<p>Тринокулярната глава има отделна вертикална тръба за монтиране на цифрова камера в нея (не е приложен). Тя е разположена вертикално. Тринокулярната тръба е оборудвана с тръби, които могат да се завъртат на 360°, и може да се регулира диоптърът на лявата тръба. Конструкцията на тринокулярната глава Ви позволява да регулирате лесно разстоянието от очите съобразно височината на наблюдаващия.</p>
<p>Револверната глава с обективи е ориентирана навътре и в нея могат да се вкарват едновременно 5 обектива – 4 обектива се получават като комплект, а един от слотовете е свободен. Допълнителен обектив ще осигури допълнително увеличение в диапазона на увеличение.</p>
<p><strong>Осветление</strong></p>
<p>Халогенна крушка 30 W осигурява ярко осветление, което гарантира добра видимост на структурите на образците с всеки метод на наблюдение и всеки използван обектив. Светлината е топла, което е добре за очите при продължителна работа. Има опция за регулиране на яркостта. Осветлението е с променливотоково захранване. </p>
<p>Осветлението на Кьолер може да се регулира благодарение на центрирания и регулируем по височина кондензер на Abbe, диафрагмата на апертурата и полевата диафрагма. На кондензера има слот, където може да се монтира плъзгач за метода на тъмното поле или за фазовоконтрастно наблюдение. Плъзгачът Ви дава възможност за лесно превключване между изследователските методи, което повишава производителността.</p>
<p><strong>Предметна маса и механизъм за фокусиране</strong> </p>
<p>Предметната маса няма рейка за позициониране, което повишава ергономичността. Механичното приспособление премества обекта плавно и може да се отстранява за ръчно сканиране.</p>
<p>От двете страни, близо до основата на микроскопа, са монтирани бутоните за фокусиране, което Ви позволява да поставите ръцете си върху масата, вместо да ги държите вдигнати при продължителна работа. Бутоните са коаксиални, т.е. те са разположени на една и съща ос. Грубото фокусиране има застопоряващ механизъм и бутон за регулиране на затягането. Механизмът за фокусиране работи плавно и поради това не е необходимо да влагате никакви усилия при регулирането.</p>
<p><strong>Принадлежности</strong></p>
<p>Гамата допълнителни принадлежности включва окуляри, обективи, устройства за поляризация, кондензери за тъмно поле, устройства за фазов контраст, плъзгачи за калибриране и цифрови камери. Конструирани специално за микроскопа MAGUS Bio 250T, устройствата се съгласуват оптимално с микроскопа и увеличават максимално неговите възможности.</p>
<p><strong>Основни характеристики на микроскопа:</strong> </p>
<ul>
<li>Тринокулярна глава с вертикална тръба за монтиране на цифров фотоапарат</li>
<li>Завъртащите се на 360° тръби на окулярите Ви дават възможност да ги регулирате по такъв начин, че да бъдат в съответствие с височината на потребителя</li>
<li>Регулиране на диоптъра на лявата тръба, грубо фокусиране с бутон за застопоряване и грубо регулиране на затягането, фино фокусиране</li>
<li>Наблюдения с преминаваща светлина, светлинен източник – халогенна лампа 30 W с регулируема яркост</li>
<li>Кондензерът на Abbe с диафрагмата на апертурата и полевата диафрагма осигуряват възможност за настройка на осветлението на Кьолер</li>
<li>Има опция за монтиране на плъзгач за фазовоконтрастно наблюдение и плъзгач за метода на тъмното поле (в кондензера има специален слот за тяхното монтиране)</li>
<li>Голям набор от допълнителни принадлежности</li>
</ul>
<p><strong>Основни характеристики на камерата:</strong></p>
<ul>
<li>Камерата работи автономно, без връзка с компютър или инсталиране на софтуер</li>
<li>Интерфейс HDMI за висока и стабилна скорост на предаване на данни</li>
<li>Разделителната способност на камерата е 1920x1080 pix – идеален избор за показване на изображения на Full HD монитор</li>
<li>60 fps за наблюдение на движещи се образци, заснемане на видеозаписи и преместване на образците без трептене или закъснения</li>
<li>Цветният CMOS сензор SONY Starvis с фоново осветление осигурява ниско ниво на шума и висока светлочувствителност дори при слаба осветеност. Ще получите по-чисти, по-ярки изображения с по-наситени цветове</li>
<li>Софтуер със заснемане на снимки и видеозаписи, редактиране, външен дисплей, линейни и ъглови измервания</li>
</ul>
<p><strong>Комплектът включва:</strong></p>
<ul>
<li>Цифрова камера MAGUS CHD10 (цифрова камера, HDMI кабел (1,5 m), USB мишка, 32 GB SD карта с памет, променливотоков захранващ адаптер 12 V/1 A (Евро), ръководство за потребителя и гаранционна карта)</li>
<li>Течнокристален монитор MAGUS MCD20</li>
<li>Основа с вход за захранване, светлинен източник за преминаваща светлина, механизъм за фокусиране, предметна маса, кондензер и револверна глава</li>
<li>Тринокулярна глава</li>
<li>Планахроматичен обектив с корекция до безкрайност: 4x/0,1</li>
<li>Планахроматичен обектив с корекция до безкрайност: 10x/0,25</li>
<li>Планахроматичен обектив с корекция до безкрайност: 40x/0,65 (пружинно натоварен)</li>
<li>Планахроматичен обектив с корекция до безкрайност: 100x/1,25 (пружинно натоварен)</li>
<li>Окуляри 10x/22 mm с голямо разстоянието от очите (2 бр.)</li>
<li>Чашки на окулярите (2 бр.)</li>
<li>Филтри (4 бр.)</li>
<li>Адаптер за камера с С-образна монтировка</li>
<li>Бутилка с имерсионно масло</li>
<li>Шестостенен ключ</li>
<li>Променливотоков захранващ кабел</li>
<li>Покривало против прах</li>
<li>Ръководство за потребителя и гаранционна карта</li>
</ul>
<p><strong>Предлагат се по заявка:</strong></p>
<ul>
<li>Окуляр 10x/22 mm със скала</li>
<li>Окуляр 12,5x/14 mm (2 бр.)</li>
<li>Окуляр 15x/15 mm (2 бр.)</li>
<li>Окуляр 20x/12 mm (2 бр.)</li>
<li>Окуляр 25x/9 mm (2 бр.)</li>
<li>Планахроматичен обектив с корекция до безкрайност: 20x/0,4</li>
<li>Планахроматичен обектив с корекция до безкрайност: 60x/0,80 (пружинно натоварен)</li>
<li>Фазовоконтрастно устройство</li>
<li>Плъзгач за фазовоконтрастно наблюдение</li>
<li>Кондензер за тъмно поле NA 0,9</li>
<li>Кондензер за метода на тъмното поле в имерсионно масло NA 1,36–1,25</li>
<li>Плъзгач за метода на тъмното поле</li>
<li>Устройство за поляризация</li>
<li>Плъзгач за калибриране</li>
</ul>
Виж повече
Допълнителна информация
Виж повече
Информация за производителя
| Контакт | [email protected] |
| Адрес | ул. Акад. Стефан Младенов 46, София, 1700, България |
| Уебсайт | https://magusmicro.bg/ |
Виж повече
Ние от PIC.bg постоянно полагаме усилия информацията на тази страница да е точна. В редки случаи съдържанието може да е некоректно. Всички снимки са с информативна цел и е възможно да съдържат аксесоари, които не са включени в стандартния пакет. Някои от спецификациите или цените могат да бъдат променяни от производителя без предизвестие или да съдържат експлоатационни грешки. Всички промоции, посочени в сайта, се предлагат до изчерпаване на количествата.
Отзиви
0.0
0 отзива.
5
0
4
0
3
0
2
0
1
0
Оцени продукта
Добави отзив